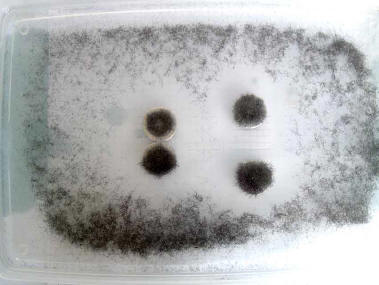

I materiali magnetici (parola chiave-interazione a distanza)
di Mancio
Materiali: olio di vasellina, lana d'acciaio, passino a maglie strette contenitore con coperchio, forbici, cucchiaino, foglio bianco A 4, calamite.
Procedura:
1) se non hai a disposizione sottile limatura di ferro, la puoi preparare sminuzzando con le forbici la lana d'acciaio, versandola nel passino e filtrandola sul foglio bianco.
2) disperdi il più possibile in maniera omogenea la lana del contenitore, aggiungi la vasellina delicatamente e il modo da coprire i pezzettini d'acciaio; chiudi il contenitore con il coperchio e se la dispersione non è sufficientemente omogenea puoi provare a migliorarla muovendo dolcemente il contenitore.
3) porrai le calamite sul foglio bianco,avvicinerai (e metterai) il contenitore (senza coperchio) alle (sulle) calamite. Osserva, disegna e /o fotografa quello che succedere anche quando nuovi il contenitore o le sottostanti calamite.